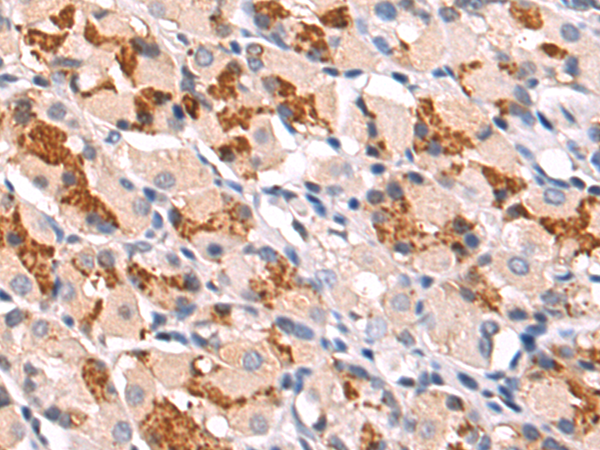

-
分类: 科研抗体货号: P04623别名: HRG3; pro-NRG3应用: WB,IHC反应种属: Human, Mouse
-
分类: 科研抗体货号: P04625别名: PGQTL2应用: WB,IHC反应种属: Human, Mouse
-
分类: 科研抗体货号: P04620别名: Rb2; P130应用: WB,IHC反应种属: Human, Mouse, Rat
-
分类: 科研抗体货号: P04614别名: AIK; ARK1; AURA; BTAK; STK6; STK7; STK15; PPP1R47应用: WB反应种属: Human
-
分类: 科研抗体货号: P04613别名: ASMD; ASOD; PTX3; CTPP4; CTRCT11应用: WB,IHC反应种属: Human, Mouse, Rat
-
分类: 科研抗体货号: P04612别名: TUP1; DGCR1; TUPLE1应用: IHC反应种属: Human, Mouse
-
分类: 科研抗体货号: P04668别名: NRC; AIB3; ASC2; PRIP; TRBP; RAP250应用: IHC反应种属: Human, Mouse
-
分类: 科研抗体货号: P04609别名: Prsp; Tasp应用: IHC反应种属: Human, Mouse, Rat
-
分类: 科研抗体货号: P04664别名: KIS; KIST; P-CIP2应用: WB反应种属: Human, Mouse, Rat
-
分类: 科研抗体货号: P04608别名: L56; HtrA; ARMD7; ORF480; PRSS11; CARASIL应用: WB,IHC反应种属: Human, Mouse, Rat

鄂公网安备42018502007531号
鄂公网安备42018502007531号

